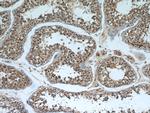
TPPII Antibody in Immunohistochemistry (Paraffin) (IHC (P))

Search
Proteintech
TPPII Monoclonal Antibody (5H6F11)
{{$productOrderCtrl.translations['antibody.pdp.commerceCard.promotion.promotions']}}
{{$productOrderCtrl.translations['antibody.pdp.commerceCard.promotion.viewpromo']}}
{{$productOrderCtrl.translations['antibody.pdp.commerceCard.promotion.promocode']}}: {{promo.promoCode}} {{promo.promoTitle}} {{promo.promoDescription}}. {{$productOrderCtrl.translations['antibody.pdp.commerceCard.promotion.learnmore']}}
产品信息
66017-1-IG
种属反应
已发表种属
宿主/亚型
分类
类型
克隆号
抗原
偶联物
形式
浓度
规格
纯化类型
保存液
内含物
保存条件
运输条件
产品详细信息
Immunogen sequence: LERLKDLPF IVSHRLSNTL SLDIHENHSF ALLGKKKSSN LTLPPKYNQP FFVTSLPDDK IPKGAGPGCY LAGSLTLSKT ELGKKADVIP VHYYLIPPPT KTKNGSKDKE KDSEKEKDLK EEFTEALRDL KIQWMTKLDS SDIYNELKET YPNYLPLYVA RLHQLDAEKE RMKRLNEIVD AANAVISHID QTALAVYIAM KTDPRPDAAT IKNDMDKQKS TLVDALCRKG CALADHLLHT QAQDGAISTD AEGKEEEGES PLDSLAETFW ETTKWTDLFD NKVLTFAYKH ALVNKMYGRG LKFATKLVEE KPTKENWKNC IQLMKLLGWT HCASFTENWL PIMYPPDYCV F (900-1249 aa encoded by BC039905)
靶标信息
This gene encodes a ubiquitously expressed transcription factor that controls cholesterol homeostasis by stimulating transcription of sterol-regulated genes. The encoded protein contains a basic helix-loop-helix-leucine zipper (bHLH-Zip) domain.
仅用于科研。不用于诊断过程。未经明确授权不得转售。
生物信息学
蛋白别名: TPP-2; TPP-II; Tripeptidyl aminopeptidase; Tripeptidyl-peptidase 2; Tripeptidyl-peptidase II; unnamed protein product
基因别名: IMD78; TPP-2; TPP-II; TPP2; TPPII
UniProt ID: (Human) P29144
Entrez Gene ID: (Human) 7174